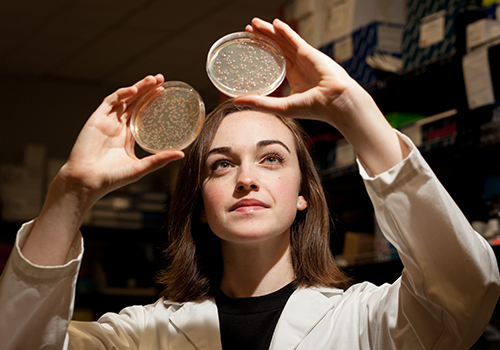
Summer of Research, Internships, and Study Abroad Await Gatton Academy  Students | Western Kentucky University

Applied Microbiology Concentration
Find Your Field in Applied Microbiology
- Medical microbiologist can be involved with research, understanding disease processes, how to prevent disease, or to develop policies to related to biomedical products, healthcare and lab research.
- Medical microbiologists can help locate the source of and track outbreaks of disease. In private diagnostic labs they may do research to develop new diagnostic tests and procedures and with more education and experience can manage a lab. They can work in public health laboratories, private diagnostic laboratories and private companies. Researchers in medical microbiology may work at government agencies such as the Center for Disease Control, the National Institutes of Health or a university
- An entry level microbiologist can start with a Bachelor's degree. Higher positions many require a Master's Degree or Ph.D.
- Median annual wage = $85,000/ year ($40,000-130,000 depending on education, experience and the position.)
- Predicted growth 7%, which is higher than average
- More labor statistics for this sector...
Those wanting to work in a hospital lab should consider a WKU-BIOL major in Medical Laboratory Science.
- Industrial microbiologists use microorganisms in manufacturing production processes. This can also include biosafety, the development of new products, and maintaining the quality in industrial processes and laboratories. Duties include insuring that regulatory policies are being followed as well as producing industrial product such as biofuels, antibiotics, pharmaceuticals,vitamins and some plastics, all of which involve microorganisms.
- Work in a laboratory, but the lab may be housed in an industrial setting. Major pharmaceutical companies (i.e. Pfizer, GSK, Eli Lily, Merck), and companies such as Proctor & Gamble and Johnson & Johnson are a couple of examples of possible employers.
- Entry level may require a B.S., but biosafety officers and lead scientists requires M.S. or Ph.D.s.
- $85,000 ($49,000-147,000)
- Predicted growth 7%, which is higher than average
- Food, agricultural and environmental microbiologists research ways to improve the efficiency and safety of agricultural establishments and products. This may include production of food products such as cheese, wine, beer, bread and yogurt."
- These microbiologists work in the laboratory, an office or in the field. Depending on the job, travel may be required. Government agencies such as the United States Department of Agriculture (USDA) and the Food and Drug Administration (FDA) are agencies that hire microbiologists. Industries such as Great Lakes Cheese Company, Budweiser, and vineyards are examples of places that might employ food microbiologists. Industries also hire Food Safety Microbiologists.
- Entry level may require a B.S., but food safety officers and lead scientists requires M.S. or Ph.D.s.
- $85,000 ($49,000-170,000)
- Predicted growth 8%, which is higher than average

Environmental Monitor
Biotechnology Manager
Service Director
Sterilization Team Leader
Quality Manager
Research Scientist
Quality Manager
Regulatory Coordinator
Biosafety Manager
Brewery Manager
Winery Manager
Lab Manager

Food/Beverage Companies
Public Health Departments
Drug Companies
Medical Device Companies
Pet Food Manufacturers
Food Manufacturers
Private Laboratories
Medical Laboratories
Universities & Colleges
Research Organizations
Environmental Organizations
Beer & Wine Companies
Bureau of Labor Statistics, U.S. Department of Labor, Occupational Outlook Handbook, Life Science Occupations
Know Your Path in Applied Microbiology
Biology & Science Core
Cells, Metabolism, & Genetics + Lab • Ecology, Evolution & Diversity + Lab • Algebra • Biophysics + Lab • Chemistry + Lab • Professional Aspects of Biology
AM Requirements
Microbial Biology & Diversity • Evolution • Molecular & Cell Biology + Lab • Statistics • or Calculus • Bioinformatics • Pathogenic Microbiology • Immunology or Food Microbiology or Applied & Environmental Microbiology or Introduction to Recombinant Genetics (3) or Virology
AM Biology Electives
[Students select 3-4 of these courses, based on their own interests, including any from the list above not taken as a requirement. Other choices include the below]
Genome Discovery Exploration • Molecular Genetics • Plant Pathology • Neurobiology • Techniques and Theory of Electron Microscopy • Cell Biology • Cell Biology Lab • Biochemistry • Biochemistry Lab • Recombinant Gene Technology • Cooperative Education in Biology • Independent Research in Biology
AM Example Courses for Selection: General Education Requirements
Health Literacy for Consumers • Personal & Public Health • Environmental Science • Food in World History • Complementary Health Care • Human Values and Health Science
This concentration has allowances for an added minor or certificate.
These would pair well:
Brewing and Distilling Arts & Sciences
Find Your Place in Applied Microbiology

The Biology Department has lots of student organizations to chose from. These clubs are great way to make friends, get involved, and enhance your experience in our department! Microbiology Club, the Student Chapter of the American Society of Microbiology is a great option for this degree concentration.

There are many opportunities to participate in research as an student in our department, from yeast cells to binding proteins and from viruses to host-bacterial interactions. Our undergrads regularly present at conferences and contribute to new discoveries! Find an AM lab that matches your interests!

An internship is a great way to get hands-on exposure to different disciplines within biology. Internships can helping you decide if your chosen career is right for you! They providing experiential hours required by many professional societies and you can get upper-level biology credit (BIOL 369).


Humans have been brewing alcohol since the dawn of recorded history. This multidisciplinary certificate is designed to complement an existing major in a related field, by providing a background understanding of topics related to the brewing and distilling industries−students need to become competitive in the marketplace.

This 21 credit hour certificate program will equip graduates for work preventing or deducting environmental hazards.You'll take classes in environmental health, principles of environmental toxicology, pollution control, water treatment, and environmental management. The certificate is offered through the School of Public Health.

Biology Ambassadors are an elite group of students who assist with recruitment, retention, and advising. They help prospective students and visitors understand that the Biology Department is truly an exceptional place.

BioCoaches are talented upper division students that serve as peer mentors and learning assistants in our introductory courses. Serving in BIOL 120 is best for AM students, and you'll receive course credit for playing a vital role in student success.

Next Chance to Register for Classes
|
Days
Loading...
|
Some of the links on this page may require additional software to view.
